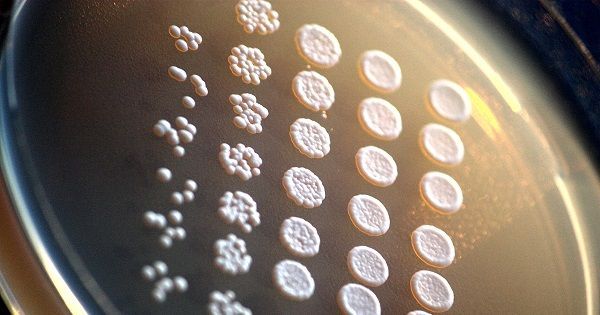

La elaboración de cerveza es muy similar a la del vino en cuanto a sus fundamentos. La gran diferencia reside en la fuente de azúcar a fermentar.
El proceso puede resumirse en cuatro grandes etapas principales.
- Obtención de azúcar a partir de granos de cereal
- Cocción del líquido azucarado
- Fermentación
- Carbonatación
Mientras en el vino el fermentable es el jugo azucarado de una fruta, la uva, los cereales para elaborar cerveza sólo disponen de almidón, el cual no es fermentable, por lo tanto requieren de un proceso adicional conocido como “maceración”.
A continuación se analizarán cada una de las etapas del proceso de hacer cerveza, pero previamente se revisarán cuáles son los ingredientes necesarios para hacer cerveza artesana.
En resumen, se requieren 4 ingredientes principales para hacer cerveza: agua, malta, lúpulo y levadura.
Ingredientes para hacer cerveza
1. Agua.

Alrededor del 90-95% de la cerveza es agua, lo que la convierte en el principal ingrediente en su elaboración y por lo general, los minerales del agua que más interesan a los cerveceros son el calcio, los sulfatos y los cloruros.
El calcio aumenta la extracción de la malta y del lúpulo durante la maceración y en la cocción, disminuyendo la turbidez en la cerveza.
El cobre, el manganeso y el zinc inhiben la floculación de las levaduras. Los sulfatos refuerzan el amargor y la sequedad del lúpulo, mientras que los cloruros otorgan una textura más plena y refuerzan el dulzor.
2. Cebada Malteada.

La malta, como ingrediente de la cerveza, es el producto que se obtiene a partir del desarrollo controlado de la germinación de granos de cereal, sobre los que luego se aplica un procedimiento de secado y tostado.
Al hacer cerveza es posible utilizar cualquier cereal que sea malteado para que sus azúcares sean fermentables, siendo la malta de cebada el grano más utilizado en la cervecería occidental.
Básicamente, los tipos de malta se pueden dividir en tres categorías:
2.1 Maltas base.

Son maltas claras, poco horneadas y con gran poder enzimático (capacidad de convertir almidón en azúcares fermentables), que suelen formar entre el 85-100% de la totalidad de la mezcla de granos al elaborar cerveza. Dentro de las maltas base más conocidas se encuentran las maltas Pilsner, Pale Ale, Munich y Vienna.
2.2 Maltas especiales.

Son maltas muy horneadas, con poco o nada de poder enzimático, que van desde el color ámbar al negro. Generalmente son usadas en pequeñas cantidades y buscan desarrollar colores y/o aromas/sabores específicos en la cerveza, dependiendo del estilo.
Existe una gran variedad de maltas especiales, entre ellas maltas negras, maltas chocolates, maltas tostadas, etc.
2.3 Maltas mixtas.

Son maltas con un proceso de horneado intenso pero que conservan propiedades enzimáticas suficientes para que puedan ser usadas como base o aditivos. En esta categoría se encuentran las maltas Cristal (Inglaterra) y las maltas Caramelo (Alemania).
2. Lúpulo.

El lúpulo (Humulus Lupulus) es una planta de la familia de las cannabáceas, prima de la Cannabis Sativa y oriunda de Europa, Asia Occidental y Norteamérica.
El lúpulo utilizado como ingrediente de la cerveza proviene de las flores femeninas de la planta denominadas “conos”, donde residen las denominadas glándulas de “lupulina”.
La lupulina es una resina de color amarillento que se transforma durante el proceso de elaboración de la cerveza, aportando aromas, sabores y capacidades de conservación antibacterianas, ayudando también a estabilizar posteriormente el proceso de formación y retención de espuma. Sus principales componentes son:
2.1 Ácidos Alfa.
Son un conjunto de resinas, principalmente humulona, cohumulona y adhumulona responsables del amargor en la cerveza. Al hervir, estas resinas sufren un proceso de transformación denominado isomerización, a partir del cual se forman los compuestos amargos que finalmente son disueltos en la cerveza, denominados ácidos iso-alfa.
2.2 Ácidos Beta.
También llamados lupulonas, son resinas con un bajo poder de amargor pero que oxidados pueden generar sabores no deseados y astringencia en la cerveza.
2.3 Aceites esenciales.
Son los responsables de otorgar sabor y aroma a la cerveza. Su cantidad y calidad son específicas para cada variedad de lúpulo, pero por lo general representan entre el 0,5 y el 3% de su masa total.
2.4 Taninos.
Son los encargados de inhibir el crecimiento bacteriano, favoreciendo el desarrollo saludable de la levadura durante la fermentación. Esta acción antibacteriana perdura en el tiempo ayudando a la conservación de la cerveza.
Los lúpulos se clasifican en tres categorías principales:
2.5 Lúpulos de amargor.
Son ricos en ácidos alfa y se añaden al inicio de la cocción. Algunos de los representantes más conocidos en esta categoría son los lúpulos Brewer’s Gold, Northern Brewer y Cascade.
2.6 Lúpulos de aroma.
Estos lúpulos aportan mayor cantidad de elementos aromáticos y se añaden al final de la cocción, o incluso después de la fermentación en un proceso denominado Dry Hopping. Algunos de sus representantes más reconocidos son el lúpulo checo Saaz, los alemanes Spalt y Tettnang, los ingleses Golding y Fuggles y los estadounidenses Cascade y Willamette.
2.7 Lúpulos mixtos.
Son lúpulos que aportan características tanto de aroma como sabor, aunque menos acentuadas. Es una categoría muy variable y sólo como ejemplo se pueden mencionar los lúpulos alemanes Hersbrucker y Hallertau, así como sus derivados botánicos.
4. Levadura

La levadura es un hongo unicelular que se reproduce asexuadamente por gemación, un proceso en donde su estructura desarrolla una yema o protuberancia que luego se convierte en un nuevo individuo.
La mayoría de los estilos de cerveza se elaboran utilizando levaduras de dos especies del tipo Saccharomyces como ingrediente de la cerveza, las cuales consumen azúcar y la transforman produciendo alcohol (etanol) y CO2 (dióxido de carbono).
A esta transformación se la conoce con el nombre de fermentación, proceso en que la levadura convierte el mosto azucarado elaborado a partir de las maltas.
Existen dos tipos básicos de levadura:
3.1 Levadura de fermentación alta (Ale)
Es la que se encuentra normalmente en la naturaleza y recibe el nombre de Saccharomyces cerevisiae. La levadura ale trabaja a temperaturas de entre 12 y 24 °C, situándose en la superficie del mosto durante la fermentación, razón por la cual son denominadas levaduras de fermentación alta.
3.2 Levadura de fermentación baja (Lager)
Estas levaduras, de la especie Saccharomyces uvarum (también denominada S. carlsbergensis), trabajan a temperaturas de entre 7 y 13 °C y se sitúan en el fondo del mosto durante la fermentación, razón por la cual se denominan levaduras lager de fermentación baja.
3.3 Levadura de fermentación espontánea (Wild)
En las llamadas cervezas de fermentación espontánea no se selecciona un tipo específico de levadura sino que se permite que todas las levaduras en suspensión en el aire se introduzcan en el mosto.
En resumen, sumado a las diversas variedades de Saccharomyces, pueden encontrarse más de 50 fermentadores diferentes entre los cuales se pueden encontrar Lactobacillus y Brettanomyces.
El paso a paso
1. Malteado
El proceso de malteado consta de tres etapas básicas: la germinación, el secado y el tostado.
1.1 Germinación
Es la primera etapa en la elaboración de toda malta. Consiste en inducir el brote de los granos de cereal para permitir la activación de las enzimas que convertirán el almidón en azúcares fermentables o enzimas amilolíticas
1.2 Secado
El objetivo de esta etapa es detener la germinación eliminando el agua que contienen las semillas empleando calor. Para no destruir las enzimas amilolíticas, la temperatura de secado no debe sobrepasar los 60ºC.
1.3 Tostado
Es el procedimiento usado con la finalidad de obtener las denominadas maltas especiales. Consiste en hornear la malta a temperaturas ascendentes y progresivas para producir maltas con diferentes grados de caramelización
1.4 Escalas Lovibond, SRM y EBC
Tres son las escalas más populares usadas para expresar el color de la cerveza: Lovibond, SRM y EBC.
El sistema Lovibond fue creado a fines del siglo IX y se basaba en la comparación del color de la cerveza con una cuadrícula de diferentes tonalidades graduadas de 0 a 20, denominadas grados Lovibond (ºL).
La escala SRM (Standard Reference Method) fue creada por la American Society of Brewing Chemists en 1950. El color es medido directamente por un instrumento denominado espectrofotómetro.
El sistema EBC fue creado por la European Brewers Convention y en un principio empleaba la comparación visual pero posteriormente asumió la tecnología del espectrofotómetro que utilizaba la SRM.
Numéricamente una unidad EBC equivale a aproximadamente 2 unidades SRM.

2. Maceración o Mashing
La maceración consiste fundamentalmente en someter una mezcla de agua caliente y granos a una temperatura estable determinada, durante un tiempo específico, con el objetivo de lograr que las enzimas de la malta (diastasas) actúen sobre los cereales y adjuntos no malteados transformando su almidón en azúcares fermentables.
Previamente se trituran los granos de cereal para exponer el endospermo y a continuación, el cervecero va estableciendo diferentes temperaturas para obtener el mayor provecho a su mezcla y obtener así un mosto rico en materia fermentable.
A partir de este momento, la maceración puede ser realizada de dos maneras diferentes; maceración simple, aplicando solo un rango de temperatura o maceración escalonada, aplicado varios rangos de forma selectiva.
2.1 Maceración Simple
En la maceración simple, la mezcla es sometida a sólo un rango de temperatura estable. Ésta debe ser mantenida entre 65 y 68ºC durante una hora. Finalmente se retira el grano sobrante y se obtiene el líquido azucarado llamado mosto.
2.2 Maceración Escalonada
La maceración escalonada consiste en someter la mezcla de granos a diversos rangos de temperaturas específicos para activar así enzimas de manera selectiva.
Proteasas
Ejerce su mayor acción dentro del rango 45 a 57°C. Se recomienda mantener esta temperatura por unos 15 o 30 minutos. De esta manera se rompen las grandes cadenas de proteínas que producen turbiedad y se libera nitrógeno asimilable por la levadura.
Beta-amilasas (amilasas β)
Con un óptimo de temperatura entre 60 y 65ºC, degrada las cadenas de almidón secuencialmente desde sus extremos libres hasta los puntos de ramificación. En el proceso se liberan grandes cantidades de moléculas de azúcar fermentable (maltosa). El tiempo recomendado para la acción de las beta-amilasas es de aproximadamente 30 minutos.
Alfa-amilasas (amilasas α)
Rompe al azar cadenas interiores de la molécula de almidón. No es altamente productora de azúcares fermentables pero sí contribuye con la beta-amilasa produciendo nuevos puntos para que ésta ejerza su acción. Posee una temperatura óptima de 67 a 75ºC, y requiere un tiempo de acción entre 45 y 60 minutos.
2.3 Influencia del pH
Las reacciones enzimáticas son en extremo dependientes del pH. Cada una posee un rango de pH muy estrecho y propio de acción. Así por ejemplo, las proteasas actúan mejor entre 5,0 y 5,5. Las beta-amilasas lo hacen entre 5,2 y 5,8, mientras que las alfa-amilasas entre 4,5 y 5,5.
Aún así, puede establecerse un rango promedio de 4,5 a 5,8 para cualquier procedimiento de elaboración artesanal de cervezas.
2.4 Gelatinización
La gelatinización es el proceso que ocurre en el grano de almidón cuando por efecto de la temperatura, éste absorbe agua, se hace soluble y se transforma en un gel. En estas condiciones el almidón se hace traslúcido y semifluido.
3. Cocción
Con este proceso se esteriliza el mosto, se acentúa el color y sobre todo se coagulan las proteínas, lo cual favorece la obtención de una cerveza más transparente. Además, es en este proceso cuando es agregado el lúpulo, el cual otorgará entre otras cosas un contrapunto de amargor al líquido azucarado y a la cerveza resultante.
Para realizar correctamente la cocción, el mosto debe ser mantenido en ebullición durante 60 a 90 minutos dependiendo del estilo de cerveza y los ingredientes utilizados.
Finalizada la cocción, se tiene un liquido a 100ºC que debe ser llevado a una temperatura entre 25 y 30ºC para que las levaduras puedan actuar y evitar el desarrollo de microorganismos contaminantes y permitir una mejor coagulación de las proteínas que pueden causar turbidez.
4. Fermentación
La reacción básica de la fermentación alcohólica puede ser representada a través de la siguiente ecuación.
4.1 Inoculación o siembra
Existen dos técnicas básicas para inocular la levadura inoculación directa y mediante la preparación de un starter de levadura.
La inoculación directa consiste en agregar la levadura, granulada o líquida, directamente al mosto. Un starter de levadura por otra parte es definido como un pequeño cultivo de levaduras que el cervecero utiliza para comenzar una serie de réplicas seriadas, hasta alcanzar el número adecuado de células necesarias.
4.2 Fermentación primaria y secundaria
La fermentación primaria es el proceso que lleva a cabo la levadura los días subsiguientes a la inoculación. Durante este proceso la mayoría de los azúcares son transformados en alcohol (Etanol) y Dióxido de Carbono (CO2).

Al hacer cerveza, la fermentación primaria se caracteriza por una gran turbulencia y un profuso burbujeo. Por lo general el proceso se considera finalizado cuando la gravedad específica (densidad) del mosto registra el mismo valor durante tres días consecutivos.
La fermentación secundaria, por otro lado, es la que transcurre luego de culminada la agitación de los primeros días. Con frecuencia, es realizada en un equipo fermentador secundario, una vez se ha extraído parte del poso de levaduras mediante decantación.
4.3 Atenuación
También llamada “atenuación aparente”, la atenuación es un concepto que tiene el objetivo de medir el decrecimiento del azúcar durante la fermentación.
Sustituye la medición directa del azúcar por una estimación más o menos precisa basada en el porcentaje de reducción de la densidad o de la gravedad específica.
4.4 Clarificación
El proceso de clasificación busca eliminar la turbidez no deseada, la cual suele derivarse de tres causas principales:
- Presencia de materia vegetal y levaduras empleadas normalmente en el proceso de fabricación. Es una turbidez si se quiere benigna, ya que puede ser corregida de forma más o menos fácil.
- Condensación de ciertas proteínas por acción del frío, fenómeno conocido en el ámbito cervecero como “chill haze”.
- Desarrollo de levaduras y bacterias contaminantes. Se evidencia por un velo blanquecino que empaña la cerveza.
Los clarificantes se califican de manera empírica en clarificantes de “olla”, de “fermentador” y de “botella”», según la fase de la elaboración de cerveza en la cual son agregados.
Irish Moss
Musgo Irlandés en español, es elaborado a partir de un alga que prolifera en la costa atlántica de Irlanda. Actúa aglutinando y precipitando proteínas suspendidas.
Es un clarificante de “olla” ya que es agregado durante la etapa de cocción del mosto, generalmente en los últimos 15 a 20 minutos.
Isinglass
El Isinglass es un colágeno obtenido a partir de la vejiga natatoria de ciertos peces, también llamado «colapez». Su mayor efectividad reside en la precipitación de las células de levadura.
Está enmarcado dentro del grupo de los clarificantes de “fermentador”, ya que debe ser agregado al final del proceso, típicamente al colocar el fermentador secundario.
Polyclar
Polyclar es la denominación comercial del polímero sintético polivinilpolipirrolidona o PVPP, clarificante usado en cervecería y en enología. Respecto a la cerveza, es especialmente efectivo contra el enturbiamiento por frío o chill haze.
Pertenece al grupo de clarificantes denominados de “botella”, ya que es común agregarlo a la cerveza terminada antes del embotellado, aunque no directamente en la botella.
4.5 Sedimentación
Luego del agregado de los agentes clarificantes, la cerveza es mantenida en reposo por unas 24 horas con el objetivo de permitir la completa precipitación de las impurezas.
5. Carbonatacion
Existen dos métodos clásicos de carbonatación que los cerveceros artesanales suelen emplear al hacer cerveza para dar a sus productos la gasificación adecuada.

CO2 directamente a la cerveza terminada utilizando cilindros presurizados.
5.1 Adición de azúcar (Priming)
Es el más popular de los métodos en el ámbito artesanal, también conocido como “cebado” o “carbonatación natural”.
El azúcar puede ser añadida de una vez a todo el lote (batch) para luego ser inmediatamente embotellado o puede ser agregada de manera directa a cada botella durante el llenado.
5.2 Fuentes de azúcar para carbonatar
Varias son las fuentes que pueden proveer el azúcar necesario para producir el gas carbónico o CO2 que se requiere al hacer cerveza artesanal. Si bien casi todas funcionan de manera adecuada, son dos las escogidas con mayor frecuencia: el azúcar común y el jarabe de maíz.
El azúcar común o sacarosa corresponde al azúcar refinado que se emplea tradicionalmente en la cocina y en la mesa.
El jarabe de maíz o glucosa es el azúcar de carbonatación por excelencia de los cerveceros estadounidenses. Posee un potencial de fermentación del 100%
6. Maduración.
La maduración o “lagering” es el proceso mediante el cual se somete a una cerveza recién elaborada (también llamada cerveza verde) a un período de reposo con la finalidad de equilibrar su sabor y afinar sus características.
7. Embotellado
Las botellas siguen constituyendo los envases de cerveza por excelencia. Las más empleadas por los fabricantes artesanales al hacer cerveza son las de 250, 330 y 500 cc.

7.2 Tapa Corona
Son las tradicionales tapas de las bebidas gaseosas, construidas en latón, una aleación de hierro y estaño, de bordes aserrados que ajustan a presión alrededor de la boca de la botella.
7.3 Llenado
Al hacer cerveza casera, por lo general se realiza el llenado de las botellas de forma manual, utilizando una simple jarra y haciéndola chorrear por el cuello, un método que puede ser suficiente si el volumen de producción es de pocos litros.
Para una elaboración mayor, se hace casi indispensable un sistema de llenado que haga la faena más eficiente y más precisa.
Fuente: The Beer Times™
Existen dos principales formas para hacer cerveza casera.
Ambas referidas a los insumos, que reciben los nombres de “Extracto” y “Todo Grano”.
1. Sistema con extracto
Sin duda, los extractos son la manera más sencilla de hacer cerveza casera, constituyendo la técnica fundamental de los cerveceros artesanales. Emplea mucho menos equipamiento que otros sistemas y además el tiempo de elaboración es menor.
Este sistema está basado en la utilización de extractos comerciales de malta, líquidos o sólidos, que son empleados directamente en la fermentación, sin pasar por el proceso de maceración.

El sistema todo extracto es por lo general, el punto de inicio de los cerveceros novatos. Para ellos se ha creado una forma práctica de sacar un mayor provecho de de los extractos acompañándolos en los kit de elaboración de cerveza artesanal que ofrecen las casas especializadas.
Éstos incluyen los extractos requeridos para fabricar determinados litros y estilos de cerveza, pero además todos los ingredientes y utensilios necesarios. Entre los ingredientes pueden hallarse lúpulos, levadura, granos no diastásicos, adjuntos, entre otros.
Los utensilios incluyen tapadora, tapas corona, cubeta para fermentación, trampa de aire, botellas, etc.
La mayoría de quienes elaboran cerveza casera han comenzado utilizando extractos de malta porque permiten saltar gran parte de los pasos en la elaboración e ir directamente a la fermentación.
2. Sistema todo grano
Conocido también como All Grain, este sistema de hacer cerveza utiliza directamente los granos como materia prima, sin la utilización de extractos.
Si bien es una metodología mucho más laboriosa proporciona al cervecero la capacidad de seleccionar y combinar los diferentes granos que utilizará en su receta de cerveza, ajustando ajustando con precisión las características organolépticas de su producto final.
La gran diferencia entre el sistema con “extracto” y el sistema “todo grano” radica en que el primero ya provee el azúcar que la levadura va a fermentar, mientras que en el segundo el cervecero debe producirla
Te gustaría dominar el arte de elaborar cerveza artesanal en casa con facilidad y en tan solo dos semanas🍺
Equipo para hacer cerveza artesanal
A continuación una lista del equipo para hacer cerveza artesanal, algunos de ellos necesarios desde una etapa básica y otros algo más avanzados que se pueden ir incorporando como parte de una mejora continua.
1. Medidor de pH
El medidor de pH es un instrumento ampliamente utilizado en la industria de las bebidas y los alimentos. En la elaboración de cervezas es usado básicamente durante la corrección del contenido mineral del agua.

2. Termómetro
El termómetro es usado fundamentalmente en el proceso de “maceración” para controlar las temperaturas de activación de las diferentes enzimas involucradas.
También es empleado en la medición de la densidad del mosto cuando se requiere corregir la lectura del hidrómetro de acuerdo a la temperatura ambiente. También es utilizable cuando se desea monitorear la temperatura en la cual transcurre la fermentación.
Tres son los tipos de termómetros generalmente utilizados al hacer cerveza.
2.1 Termómetro de alcohol
Con un rango que generalmente está entre -20 y 110ºC. Por su versatilidad puede ser usado en cualquier etapa de la elaboración.
2.2 Termómetro digital
Se presenta en una gran variedad de modelos y precios. Muestra un desempeño similar al termómetro de alcohol pero con la ventaja de alcanzar la lectura final en un tiempo muy corto.
2.3 Termómetro adhesivo
Consiste de una banda plástica que se puede fijar a la pared externa del fermentador. Poseen rangos de temperatura muy pequeños, por lo que suelen ser utilizados únicamente para monitorear la fermentación.

3.Macerador (Mash Tun)
En general, un macerador es un recipiente utilizado para mantener sumergida una sustancia sólida en un líquido durante un tiempo para extraer de ella las partes solubles.
Al hacer cerveza, el macerador se emplea en el proceso de transformación del almidón de los granos en azúcares fermentables .

4. Densímetros
Un densímetro es un instrumento empleado para hacer seguimiento al proceso de fermentación y determinar su punto final. Así mismo, para medir la cantidad aproximada de azúcar presente en el mosto antes de iniciar la fermentación.
La primera escala corresponde a la densidad y expresa la relación entre la densidad de la cerveza y la densidad del agua pura. La segunda escala corresponde al alcohol potencial. Ésta indica la concentración de alcohol que teóricamente se obtendrá una vez culminada la fermentación.
La tercera y última escala que muestra el hidrómetro corresponde a la concentración de azúcar antes de iniciada la fermentación. Expresa la cantidad de grados Brix o Plató, y cada uno de estos grados equivale a 1% de azúcar. Es decir, un grado Brix o Plató es igual a un gramo de azúcar por cada 100 gramos de mosto.

5. Fermentadores
Los fermentadores, en general, son recipientes destinados a contener, aislar y proteger el medio de cultivo al hacer cerveza durante la fermentación, habitualmente con controladores de temperatura, de gases y de pH, entre otros parámetros
Los fermentadores utilizados en la elaboración de cerveza casera casi siempre carecen de controladores, y solo utilizan válvulas llamadas airlocks que permiten mantener un ambiente anaerobio (carente de aire) durante el proceso.

6. Trampas de aire (Airlock)
Las trampas de aire o airlocks en inglés, son pequeñas válvulas plásticas que se insertan en las tapas de los fermentadores con la finalidad de impedir el ingreso del aire y de agentes contaminantes. A la vez, permiten la salida del CO2 que se produce durante el proceso.

7. Tapadora corona
La tapadora o “chapadora”, permite colocar las tradicionales tapas corona a las botellas de cerveza y de gaseosas.

8. Enfriador de mosto (Chiller)
El enfriador de mosto o chiller es utilizado inmediatamente luego de culminar la etapa de cocción para enfriar el mosto a una temperatura tolerable para la levadura.
Permite enfriar de manera rápida el mosto caliente que proviene de la etapa de cocción. Con esto se consigue, por un lado, evitar el crecimiento microbiano que pueda producirse a consecuencia de un enfriamiento lento. Además, hace que coagulen las proteínas suspendidas, lo cual resulta en una cerveza más clara.
También están los enfriadores de placas, que permiten un intercambio de calor mucho más rápido, para una mayor cantidad de litros, pero de mayor precio.

9. Pico de llenado Ferrari
Es un dispositivo empleado en la etapa de llenado de la elaboración de cerveza casera que funciona mediante gravedad.
Su modo de uso es muy sencillo, sólo basta introducirlo en la botella, conectar la manguera de sifón a la cánula lateral y presionar el botón de carga para que comience el vertido. Alcanzado el nivel predeterminado, el llenado es detenido de manera automática.

10. Olla de cocción
Utilizada para el hervido y lupulizado del mosto. Las más utilizadas son las de acero inoxidable con capacidad para 20 litros de agua o más, muy convenientes para los lotes artesanales. Se aconseja no emplear las de aluminio para evitar reacciones indeseables durante la elaboración.

11. Quemadores
Permiten calentar volúmenes más o menos grandes de mosto, lo cual sería dificultoso en una estufa doméstica. Pueden ser eléctricos pero los más comunes son los de gas propano.

12. Agitador magnético
De uso común en los laboratorios, un agitador magnético es un aparato que, mediante un campo magnético generado en su interior, hace girar una pequeña barra plástica con núcleo metálico. Dicha barra, a su vez, agita el líquido donde está sumergida. Es empleado para realizar la propagación de cultivos de levadura.

13. Tomamuestras
Consiste en un tubo de agujeros estrechos que funcionan como pipeta de laboratorio y permite tomar muestras del mosto o la cerveza durante todo el proceso. Solo requiere sumergir un extremo en el líquido, tapar con el dedo el agujero libre y retirarlo para finalmente ser vaciado en otro recipiente.

14. Autosifón
Un autosifón es un útil artefacto que permite decantar la cerveza recién clarificada sin arrastrar los sedimentos. Consiste de un tubo plástico conectado a una manguera que, mediante el movimiento de un émbolo, succiona el líquido delicadamente para luego dejarlo caer por gravedad. Funciona de manera similar a una bomba manual.

15. Molino
El molino es utilizado para romper la cáscara de los granos de malta de cebada y facilitar la extracción del almidón en la maceración. El más simple es el de accionamiento manual que se usa de manera casera para moler semillas, carne y otros alimentos.
16. Escurridor
El escurridor de botellas es un soporte para botellas que permite su secado espontáneo luego del lavado o de la sanitización. La modalidad más común es el tipo árbol (con un eje central y las botellas en las ramificaciones). Puede ser de 45 ó 90 puestos.
Ok… Brewers Friends tienes todo lo necesario para EMPRENDER..
Elaborar Cerveza Artesanal es y seguirá siendo uno de los emprendimientos más lucrativos y atractivos para muchos..
🔥Imagina realizar tu Propia Cerveza?🍺
🔥Imagina ponerle tu toqué personal a tu Cerveza.🍺
💥No te quedes por fuera
👉 Aprende a hacer tus propias Cervezas
🤩Te damos 7 DIAS DE GARANTÍA para que lo pruebes y si no te gusta. Se te devolverá el 100% de tu dinero.
Deja tu comentario si eres apasionado Cervecero 🍻
😍COMPARTE ESTO EN TUS REDES.
Pingback: 6 Ideas para hacer dinero en el mercado cervecero. – Live off Beer
Pingback: Tipos de cervezas – Live off Beer